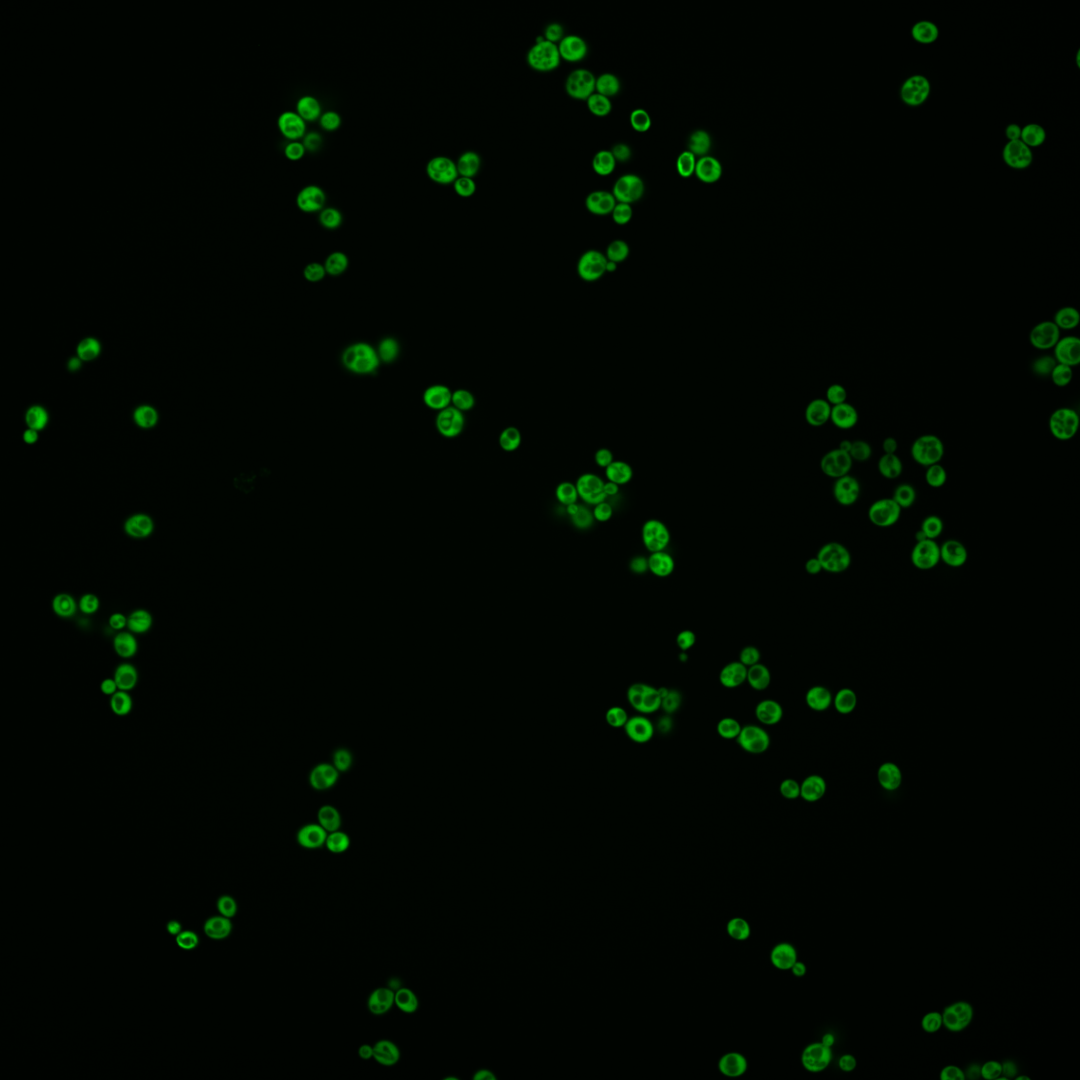
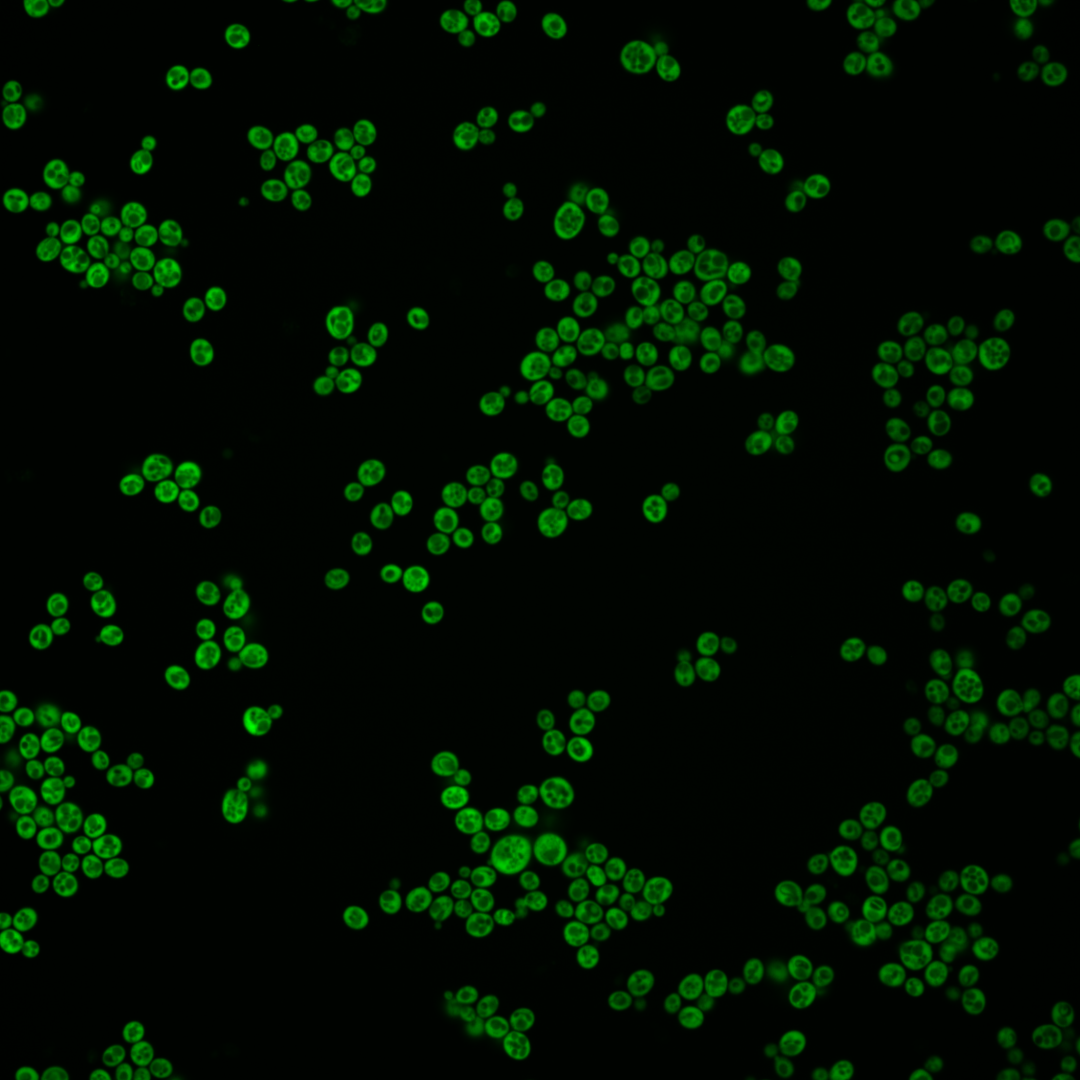
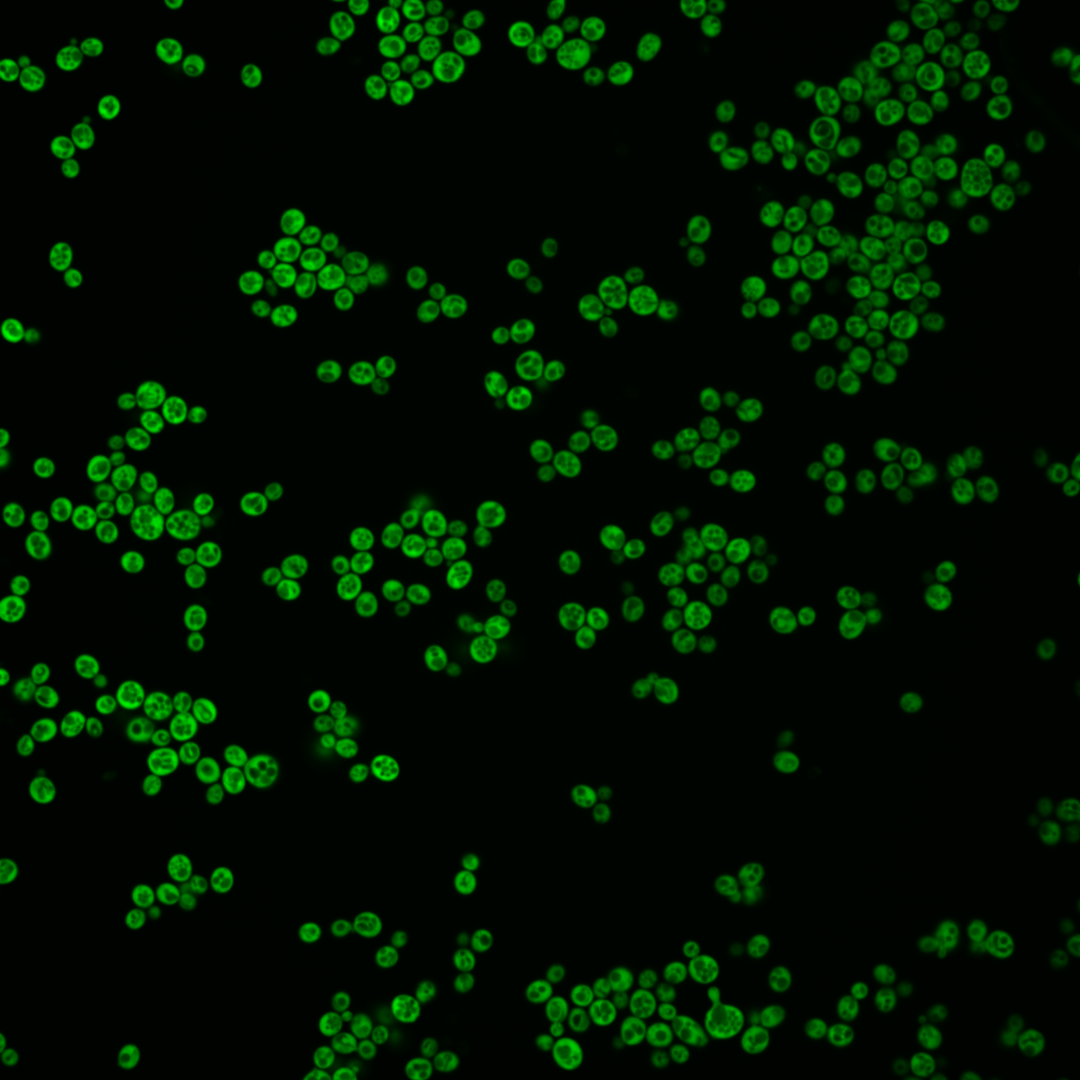
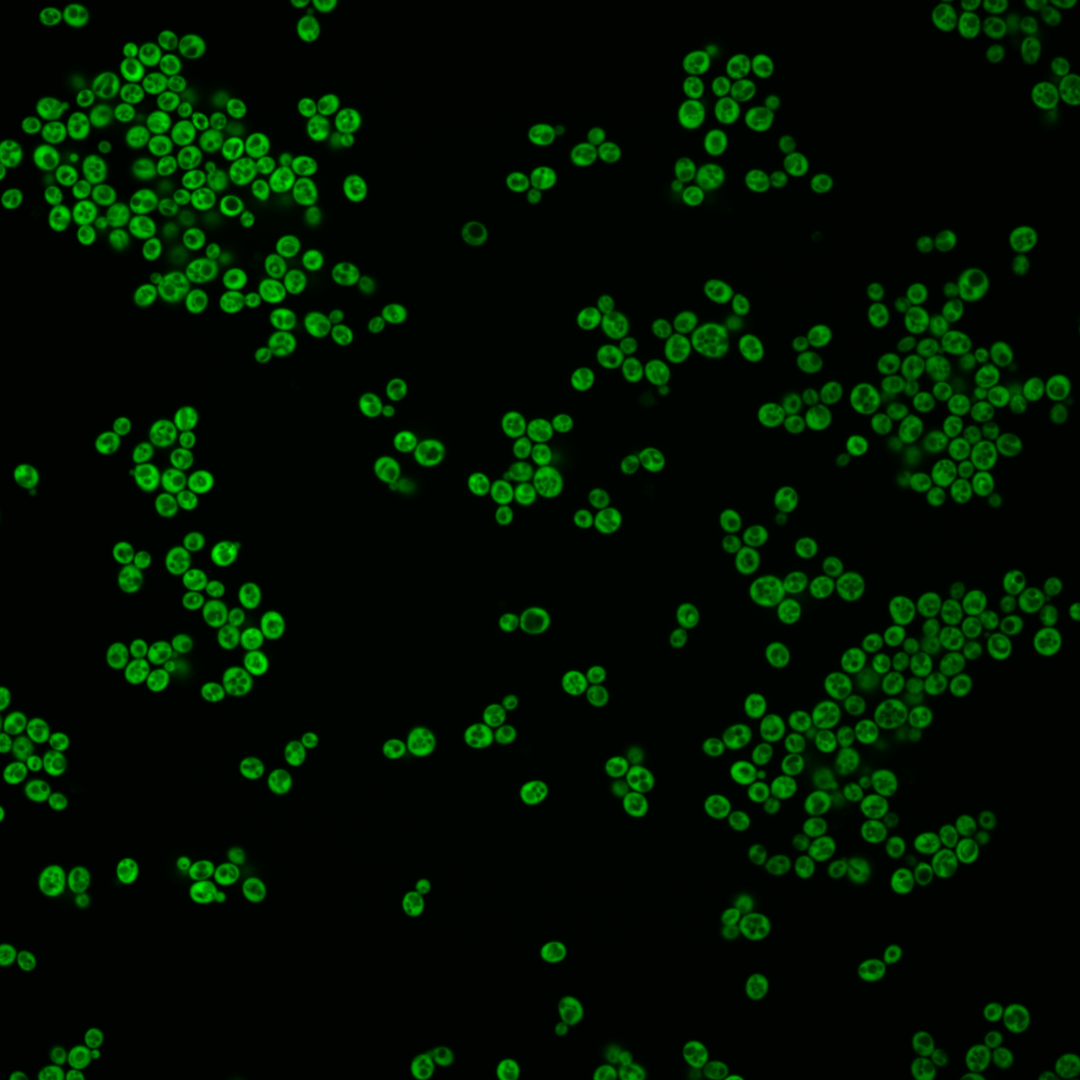

| Standard name | |
|---|---|
| Human Ortholog | |
| Description | Alpha aminoadipate reductase; catalyzes the reduction of alpha-aminoadipate to alpha-aminoadipate 6-semialdehyde, which is the fifth step in biosynthesis of lysine; activation requires posttranslational phosphopantetheinylation by Lys5p |
Micrographs




















































































Sub-cellular Localization
Yeast GFP Assignment
Protein Abundance
Localization Change
External localization resources
| ensLOC | DeepLoc | |||||||||||||||||||||||
|---|---|---|---|---|---|---|---|---|---|---|---|---|---|---|---|---|---|---|---|---|---|---|---|---|
| Localization | WT1 | WT2 | WT3 | RAP60 | RAP140 | RAP220 | RAP300 | RAP380 | RAP460 | RAP540 | RAP620 | RAP700 | HU80 | HU120 | HU160 | rpd3Δ_1 | rpd3Δ_2 | rpd3Δ_3 | WT1 | WT2 | WT3 | AF100 | AF140 | AF180 |
| Cortical Patches | 0 | 0 | 0 | 0 | 0 | 0 | 2 | 8 | 8 | – | 14 | 14 | 0 | 0 | 0 | 1 | 1 | 0 | 0 | 0 | 0 | 0 | 0 | 2 |
| Bud | 0 | 9 | 0 | 0 | 0 | 0 | 1 | 1 | 3 | – | 1 | 2 | 0 | 1 | 1 | 3 | 0 | 1 | 1 | 4 | 0 | 7 | 4 | 11 |
| Bud Neck | 0 | 0 | 0 | 0 | 0 | 0 | 0 | 0 | 0 | – | 0 | 0 | 0 | 0 | 0 | 0 | 0 | 0 | 0 | 0 | 0 | 0 | 0 | 0 |
| Bud Site | 0 | 0 | 0 | 0 | 0 | 0 | 0 | 0 | 0 | – | 0 | 0 | 0 | 0 | 0 | 0 | 0 | 0 | – | – | – | – | – | – |
| Cell Periphery | 6 | 8 | 4 | 2 | 9 | 10 | 16 | 18 | 20 | – | 31 | 33 | 7 | 5 | 13 | 13 | 6 | 6 | 0 | 0 | 0 | 0 | 0 | 0 |
| Cytoplasm | 365 | 487 | 369 | 272 | 329 | 224 | 233 | 247 | 228 | – | 159 | 196 | 449 | 537 | 584 | 439 | 321 | 397 | 344 | 476 | 367 | 353 | 430 | 566 |
| Endoplasmic Reticulum | 0 | 2 | 7 | 3 | 16 | 10 | 30 | 20 | 20 | – | 11 | 27 | 4 | 8 | 13 | 20 | 17 | 21 | 1 | 1 | 3 | 7 | 15 | 22 |
| Endosome | 0 | 0 | 0 | 0 | 0 | 0 | 0 | 0 | 0 | – | 0 | 0 | 0 | 0 | 0 | 2 | 1 | 1 | 0 | 0 | 0 | 0 | 0 | 0 |
| Golgi | 0 | 0 | 0 | 0 | 0 | 0 | 0 | 1 | 3 | – | 0 | 1 | 0 | 0 | 1 | 2 | 0 | 0 | 0 | 0 | 0 | 0 | 0 | 0 |
| Mitochondria | 0 | 0 | 0 | 0 | 0 | 0 | 0 | 3 | 6 | – | 12 | 7 | 0 | 0 | 0 | 0 | 1 | 1 | 1 | 0 | 0 | 0 | 0 | 0 |
| Nucleus | 0 | 1 | 0 | 0 | 0 | 0 | 1 | 0 | 0 | – | 0 | 0 | 0 | 0 | 0 | 1 | 1 | 0 | 0 | 0 | 0 | 0 | 0 | 0 |
| Nuclear Periphery | 0 | 0 | 0 | 0 | 0 | 0 | 0 | 0 | 0 | – | 0 | 0 | 0 | 0 | 0 | 0 | 0 | 0 | 0 | 0 | 0 | 0 | 0 | 1 |
| Nucleolus | 0 | 0 | 0 | 0 | 0 | 0 | 0 | 1 | 0 | – | 0 | 0 | 0 | 0 | 0 | 1 | 0 | 0 | 0 | 0 | 0 | 0 | 0 | 0 |
| Peroxisomes | 0 | 1 | 0 | 0 | 0 | 0 | 0 | 0 | 0 | – | 0 | 0 | 0 | 0 | 0 | 0 | 0 | 2 | 0 | 0 | 0 | 0 | 0 | 0 |
| SpindlePole | 0 | 0 | 0 | 0 | 0 | 0 | 0 | 0 | 0 | – | 0 | 0 | 0 | 0 | 0 | 2 | 1 | 0 | 0 | 0 | 0 | 0 | 0 | 0 |
| Vac/Vac Membrane | 0 | 1 | 0 | 0 | 0 | 0 | 0 | 0 | 0 | – | 2 | 2 | 0 | 0 | 0 | 13 | 9 | 5 | 1 | 6 | 2 | 2 | 2 | 3 |
| Unique Cell Count | 366 | 491 | 374 | 276 | 346 | 234 | 272 | 280 | 264 | 195 | 252 | 454 | 546 | 598 | 459 | 333 | 404 | 356 | 493 | 377 | 378 | 459 | 619 | |
| Labelled Cell Count | 371 | 509 | 380 | 277 | 354 | 244 | 283 | 299 | 288 | 230 | 282 | 460 | 551 | 612 | 497 | 358 | 434 | 356 | 493 | 377 | 378 | 459 | 619 | |
Yeast GFP Assignment
Protein Abundance
| Screen | WT1 | WT2 | WT3 | RAP60 | RAP140 | RAP220 | RAP300 | RAP380 | RAP460 | RAP540 | RAP620 | RAP700 | HU80 | HU120 | HU160 | rpd3Δ_1 | rpd3Δ_2 | rpd3Δ_3 | AF100 | AF140 | AF180 |
|---|---|---|---|---|---|---|---|---|---|---|---|---|---|---|---|---|---|---|---|---|---|
| Mean Cell GFP Intensity (1e-4) | 167.3 | 140.7 | 86.5 | 85.9 | 72.7 | 55.1 | 47.2 | 40.6 | 36.4 | – | 30.2 | 30.3 | 105.1 | 96.4 | 83.8 | 122.2 | 132.6 | 125.8 | 118.2 | 129.6 | 124.0 |
| Std Deviation (1e-4) | 35.0 | 30.8 | 18.4 | 17.5 | 15.7 | 12.8 | 12.7 | 10.4 | 9.3 | – | 8.7 | 8.0 | 25.7 | 21.1 | 19.1 | 49.0 | 54.8 | 50.5 | 29.9 | 29.8 | 33.8 |
| Intensity Change (Log2) | – | – | – | -0.01 | -0.25 | -0.65 | -0.87 | -1.09 | -1.25 | – | -1.52 | -1.51 | 0.28 | 0.16 | -0.05 | 0.5 | 0.62 | 0.54 | 0.45 | 0.58 | 0.52 |
Localization Change
| Localization | RAP60 | RAP140 | RAP220 | RAP300 | RAP380 | RAP460 | RAP540 | RAP620 | RAP700 | HU80 | HU120 | HU160 | rpd3Δ_1 | rpd3Δ_2 | rpd3Δ_3 |
|---|---|---|---|---|---|---|---|---|---|---|---|---|---|---|---|
| Cortical Patches | 0 | 0 | 0 | 0 | 0 | 0 | – | 0 | 4.6 | 0 | 0 | 0 | 0 | 0 | 0 |
| Bud | 0 | 0 | 0 | 0 | 0 | 0 | – | 0 | 0 | 0 | 0 | 0 | 0 | 0 | 0 |
| Bud Neck | 0 | 0 | 0 | 0 | 0 | 0 | – | 0 | 0 | 0 | 0 | 0 | 0 | 0 | 0 |
| Bud Site | 0 | 0 | 0 | 0 | 0 | 0 | – | 0 | 0 | 0 | 0 | 0 | 0 | 0 | 0 |
| Cell Periphery | 0 | 1.5 | 2.6 | 3.5 | 3.8 | 4.3 | – | 7.0 | 6.3 | 0 | 0 | 1.3 | 1.8 | 0 | 0 |
| Cytoplasm | -0.1 | -2.8 | -2.3 | -6.5 | -5.7 | -6.2 | – | -7.5 | -8.6 | 0.3 | -0.4 | -1.1 | -2.5 | -2.0 | -0.4 |
| Endoplasmic Reticulum | 0 | 2.1 | 1.7 | 4.9 | 3.4 | 3.5 | – | 2.4 | 4.8 | 0 | -0.5 | 0.3 | 2.0 | 2.4 | 2.5 |
| Endosome | 0 | 0 | 0 | 0 | 0 | 0 | – | 0 | 0 | 0 | 0 | 0 | 0 | 0 | 0 |
| Golgi | 0 | 0 | 0 | 0 | 0 | 0 | – | 0 | 0 | 0 | 0 | 0 | 0 | 0 | 0 |
| Mitochondria | 0 | 0 | 0 | 0 | 0 | 0 | – | 0 | 0 | 0 | 0 | 0 | 0 | 0 | 0 |
| Nucleus | 0 | 0 | 0 | 0 | 0 | 0 | – | 0 | 0 | 0 | 0 | 0 | 0 | 0 | 0 |
| Nuclear Periphery | 0 | 0 | 0 | 0 | 0 | 0 | – | 0 | 0 | 0 | 0 | 0 | 0 | 0 | 0 |
| Nucleolus | 0 | 0 | 0 | 0 | 0 | 0 | – | 0 | 0 | 0 | 0 | 0 | 0 | 0 | 0 |
| Peroxisomes | 0 | 0 | 0 | 0 | 0 | 0 | – | 0 | 0 | 0 | 0 | 0 | 0 | 0 | 0 |
| SpindlePole | 0 | 0 | 0 | 0 | 0 | 0 | – | 0 | 0 | 0 | 0 | 0 | 0 | 0 | 0 |
| Vacuole | 0 | 0 | 0 | 0 | 0 | 0 | – | 0 | 0 | 0 | 0 | 0 | 3.3 | 0 | 0 |
External localization resources
Images






























Protein Concentration and Protein Localization Data
| R1 | R2 | R3 | ||||||||||||||||
|---|---|---|---|---|---|---|---|---|---|---|---|---|---|---|---|---|---|---|
| G1 Pre-START | G1 Post-START | S/G2 | Metaphase | Anaphase | Telophase | G1 Pre-START | G1 Post-START | S/G2 | Metaphase | Anaphase | Telophase | G1 Pre-START | G1 Post-START | S/G2 | Metaphase | Anaphase | Telophase | |
| Concentration | 165.0464 | 196.2947 | 190.156 | 179.3442 | 181.2144 | 186.6416 | 115.8505 | 182.8007 | 164.8264 | 164.5933 | 174.1823 | 152.0211 | 154.4621 | 203.3966 | 184.6697 | 176.0174 | 163.7855 | 181.3395 |
| Actin | 0.0002 | 0.0002 | 0.0002 | 0.0001 | 0.0002 | 0.0001 | 0.0068 | 0.0005 | 0.0046 | 0.0001 | 0.0004 | 0.0005 | 0.0008 | 0.0001 | 0.0128 | 0.0002 | 0.0002 | 0.0006 |
| Bud | 0.0004 | 0.0005 | 0.0006 | 0.0007 | 0.0004 | 0.0004 | 0.0034 | 0.0005 | 0.0016 | 0.001 | 0.0005 | 0.0008 | 0.0017 | 0.0001 | 0.0017 | 0.0008 | 0.0002 | 0.0002 |
| Bud Neck | 0.0009 | 0.0014 | 0.0016 | 0.001 | 0.0026 | 0.0044 | 0.0006 | 0.0004 | 0.0008 | 0.0008 | 0.0013 | 0.002 | 0.0005 | 0.0003 | 0.0009 | 0.0007 | 0.0003 | 0.0011 |
| Bud Periphery | 0.0006 | 0.0006 | 0.0007 | 0.0004 | 0.0007 | 0.0002 | 0.0043 | 0.0003 | 0.0008 | 0.0005 | 0.0002 | 0.0009 | 0.0011 | 0 | 0.0022 | 0.0006 | 0 | 0.0001 |
| Bud Site | 0.0002 | 0.0007 | 0.0003 | 0.0002 | 0.0001 | 0 | 0.0016 | 0.0006 | 0.0006 | 0.0003 | 0.0001 | 0.0001 | 0.0013 | 0.0002 | 0.0027 | 0.0006 | 0.0001 | 0 |
| Cell Periphery | 0.055 | 0.0659 | 0.0465 | 0.0218 | 0.0428 | 0.0039 | 0.0377 | 0.0235 | 0.0319 | 0.0692 | 0.0041 | 0.0097 | 0.0152 | 0.0058 | 0.0119 | 0.0395 | 0.0005 | 0.0006 |
| Cytoplasm | 0.6072 | 0.7619 | 0.7166 | 0.7002 | 0.806 | 0.8605 | 0.6466 | 0.9296 | 0.834 | 0.7795 | 0.9201 | 0.8576 | 0.8474 | 0.9741 | 0.8927 | 0.7567 | 0.8587 | 0.9714 |
| Cytoplasmic Foci | 0.0003 | 0.0003 | 0.0004 | 0.0004 | 0.0005 | 0.0007 | 0.0323 | 0.0006 | 0.0091 | 0.0008 | 0.0014 | 0.0032 | 0.0043 | 0.0002 | 0.0043 | 0.0025 | 0.0587 | 0.0015 |
| Eisosomes | 0.0001 | 0.0004 | 0.0001 | 0 | 0 | 0 | 0.0008 | 0 | 0.0002 | 0 | 0 | 0.0001 | 0.0006 | 0 | 0.0001 | 0.0004 | 0.0002 | 0 |
| Endoplasmic Reticulum | 0.065 | 0.0175 | 0.021 | 0.0026 | 0.0052 | 0.0376 | 0.0398 | 0.0079 | 0.008 | 0.001 | 0.0022 | 0.0266 | 0.0123 | 0.0027 | 0.0048 | 0.0014 | 0.0007 | 0.0106 |
| Endosome | 0.0012 | 0.0005 | 0.0009 | 0.0015 | 0.0011 | 0.0019 | 0.029 | 0.0005 | 0.0018 | 0.0008 | 0.0022 | 0.0028 | 0.002 | 0.0002 | 0.0022 | 0.001 | 0.0016 | 0.0018 |
| Golgi | 0.0001 | 0.0001 | 0.0001 | 0 | 0 | 0.0001 | 0.0019 | 0.0002 | 0.0019 | 0.0001 | 0.0002 | 0.0007 | 0.0003 | 0 | 0.0008 | 0.0001 | 0.0002 | 0.0002 |
| Lipid Particles | 0.0016 | 0.0019 | 0.0016 | 0.0008 | 0.0013 | 0.0003 | 0.0102 | 0.0021 | 0.0051 | 0.0028 | 0.0009 | 0.0016 | 0.0023 | 0.0003 | 0.002 | 0.0027 | 0.0069 | 0.0003 |
| Mitochondria | 0.0019 | 0.0003 | 0.0002 | 0.0001 | 0.0002 | 0.0002 | 0.0098 | 0.0003 | 0.0031 | 0.0002 | 0.0001 | 0.0072 | 0.0076 | 0.0001 | 0.0038 | 0.0045 | 0.0032 | 0.0002 |
| None | 0.0011 | 0.0002 | 0.0003 | 0.0001 | 0.0001 | 0.0001 | 0.0153 | 0.0007 | 0.0027 | 0.0004 | 0.0004 | 0.0096 | 0.0084 | 0.0003 | 0.0033 | 0.0159 | 0.0192 | 0.0002 |
| Nuclear Periphery | 0.0559 | 0.0116 | 0.0181 | 0.0091 | 0.0115 | 0.0137 | 0.0333 | 0.0046 | 0.0065 | 0.0138 | 0.003 | 0.0108 | 0.0117 | 0.0033 | 0.0052 | 0.0094 | 0.0039 | 0.003 |
| Nucleolus | 0.0016 | 0.0005 | 0.0011 | 0.0005 | 0.0004 | 0.0001 | 0.0297 | 0.0003 | 0.0038 | 0.0024 | 0.0002 | 0.023 | 0.0109 | 0.0001 | 0.0025 | 0.0092 | 0.012 | 0 |
| Nucleus | 0.0112 | 0.0049 | 0.0067 | 0.0073 | 0.0068 | 0.0061 | 0.0148 | 0.002 | 0.0041 | 0.006 | 0.0023 | 0.0111 | 0.0119 | 0.0012 | 0.0033 | 0.0151 | 0.0039 | 0.0018 |
| Peroxisomes | 0 | 0 | 0 | 0 | 0 | 0 | 0.0013 | 0 | 0.001 | 0.0001 | 0 | 0.0001 | 0.0004 | 0 | 0.0008 | 0.0002 | 0.0007 | 0 |
| Punctate Nuclear | 0 | 0 | 0.0001 | 0 | 0 | 0 | 0.0021 | 0.0001 | 0.0003 | 0.0001 | 0.0001 | 0.0002 | 0.0025 | 0 | 0.0006 | 0.0006 | 0.007 | 0.0001 |
| Vacuole | 0.1753 | 0.1249 | 0.1648 | 0.225 | 0.1091 | 0.0617 | 0.068 | 0.0243 | 0.0708 | 0.1089 | 0.0543 | 0.0248 | 0.0442 | 0.0104 | 0.0375 | 0.1186 | 0.0164 | 0.0053 |
| Vacuole Periphery | 0.02 | 0.0057 | 0.0182 | 0.0283 | 0.011 | 0.0079 | 0.0105 | 0.001 | 0.0073 | 0.0112 | 0.006 | 0.0065 | 0.0126 | 0.0004 | 0.0038 | 0.0194 | 0.0054 | 0.0009 |
Sequencing Data
| R1 | R2 | |||||||||
|---|---|---|---|---|---|---|---|---|---|---|
| G1 Post-START | S/G2 | Metaphase | Anaphase | Telophase | G1 Post-START | S/G2 | Metaphase | Anaphase | Telophase | |
| Gene Expression | 179.4121 | 178.912 | 161.3091 | 186.4966 | 214.3008 | 203.4587 | 251.6578 | 225.1808 | 206.7505 | 214.2114 |
| Translational Efficiency | 1.5403 | 1.587 | 1.4322 | 1.1878 | 1.2465 | 1.7459 | 1.3162 | 1.0771 | 1.0692 | 1.1025 |
Hit Data
| Dataset | Hit |
|---|---|
| Protein Concentration | ✘ |
| Protein Localization | ✘ |
| Gene Expression | ✘ |
| Translational Efficiency | ✘ |
Endocytosis
| Temp | Actin Patch (Sac6-tdTomato) | Cortical Patch (Sla1-GFP) | Late Endosome (Snf7-GFP) | Vacuole (Vph1-GFP) |
|---|---|---|---|---|
| 37℃ | ||||
| RT |
Cell Cycle Omics
CYCLoPs (Lys2-GFP)
| Gene / Allele | Actin Patch (Sac6-tdTomato) | Cortical Patch (Sla1-GFP) | Late Endosome (Snf7-GFP) | Vacuole (Sac6-tdTomato) |
|---|
| Gene | Images |
|---|
| Gene | Images |
|---|
Images are not yet available
Images are not yet available